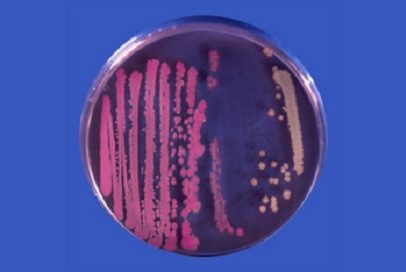

Detección de E.coli verotoxigénico O157
E.coli verotoxigénico, medios de cultivo para su detección
La ingestión de alimentos contaminados con E.coli verotoxigénico O157 provoca serios episodios que a menudo acaban en la muerte de las personas afectadas.
Esta cepa letal de E.coli se detecta tras enriquecer el alimento o el agua en el medio:
1-E. coli O157 Broth mTSB (BASE)
Enriquecimiento selectivo de E. coli O157:H7 en alimentos (carne de vacuno y
otros animales), aguas y otras muestras. (ISO 16654:2002)
Tras enriquecer en caldo O157 m-TSB (BCD165), no más de 18-24 h a 41,5°C aproximadamente:
https://www.microkit.es/fichas/E-coli-O157-BROTH.pdf
Estriar este caldo enriquecido en agar Sorbitol MacConkey o en Cromokit O157 Agar.
Inocular en superficie del agar elegido la muestra y sus diluciones para obtener muchas colonias bien aisladas:
2-Mac CONKEY SORBITOL AGAR
Detección presuntiva de E.coli serovar. O157 (UNE-EN ISO 16654:2002) a partir de alimentos (carne de vacuno,…), aguas y otras muestras, previamente enriquecidas en E. coli O157 Broth.
Incubar a 37 ºC aproximadamente durante no más de18-24 horas.
E. coli enterohemorrágico, serovariedad O157 H7 crece con colonias casi incoloras, rosa pálido-amarillentas, al no fermentar el sorbitol, de 1 mm de diámetro (estría derecha de la foto).
Las otras cepas de E. coli crecen con colonias púrpuras (estría izquierda de la foto).
Resembrar colonias sospechosas, bien aisladas, en Agar Nutritivo para E.coli
O157 (DMT126):
https://www.microkit.es/fichas/NUTRIENT-AGAR-SALMONELLA-E-COLI-O157-YERSINIA-VIBRIO.pdf
Incubar 18 h a 37°C aproximadamente.
Si se prolonga la incubación, la distinción de colonias será más difícil.
Confirmar con los tests adecuados:
Indol en Agua de triptona con triptófano (BCD129), 24 h a 37°C aproximadamente y adición de Kovacs (SBH056).
Según un método bastante difundido, si se añaden 0’1 g/l de MUG (SKL061) en el medio antes
de autoclavar, las colonias de E. coli O157 H7 son las NO fluorescentes bajo luz de 366 nm (VMT050).
https://www.microkit.es/fichas/Mac-CONKEY-SORBITOL-O157-AGAR.pdf
Más recientemente, se emplea la estría en el medio cromogénico Cromokit-O157 Agar:
3-CROMOKIT O157:H7 AGAR
Detección diferencial de E.coli enterohemorrágico (VTEC) en alimentos y muestras ambientales. Medio cromogénico con base del medio de Rappaport y Henigh
Sembrar en superficie en estría por agotamiento para aislar colonias tras el
enriquecimiento en el medio E.coli O157 Broth BCD165. Incubar 18-24 h a
35-37°C, para mayor selectividad a 44,5ºC.
Se condidera E.coli O157:H7 toda colonia pequeña de color rosa, púrpura o
magenta, ya que este es el color que desarrolla enzimáticamente la mezcla
cromogénica en esta cepa. Las demás E.coli crecen con colonias verdes o
azules, a causa de su actividad X-Glu+, sorbitol + y Lysina-.
https://www.microkit.es/fichas/CROMOKIT-O157-AGAR.pdf
Solicite precios actualizados en microkit@microkit.es
Haga sus pedidos de todas estas soluciones en pedidos@microkit.es